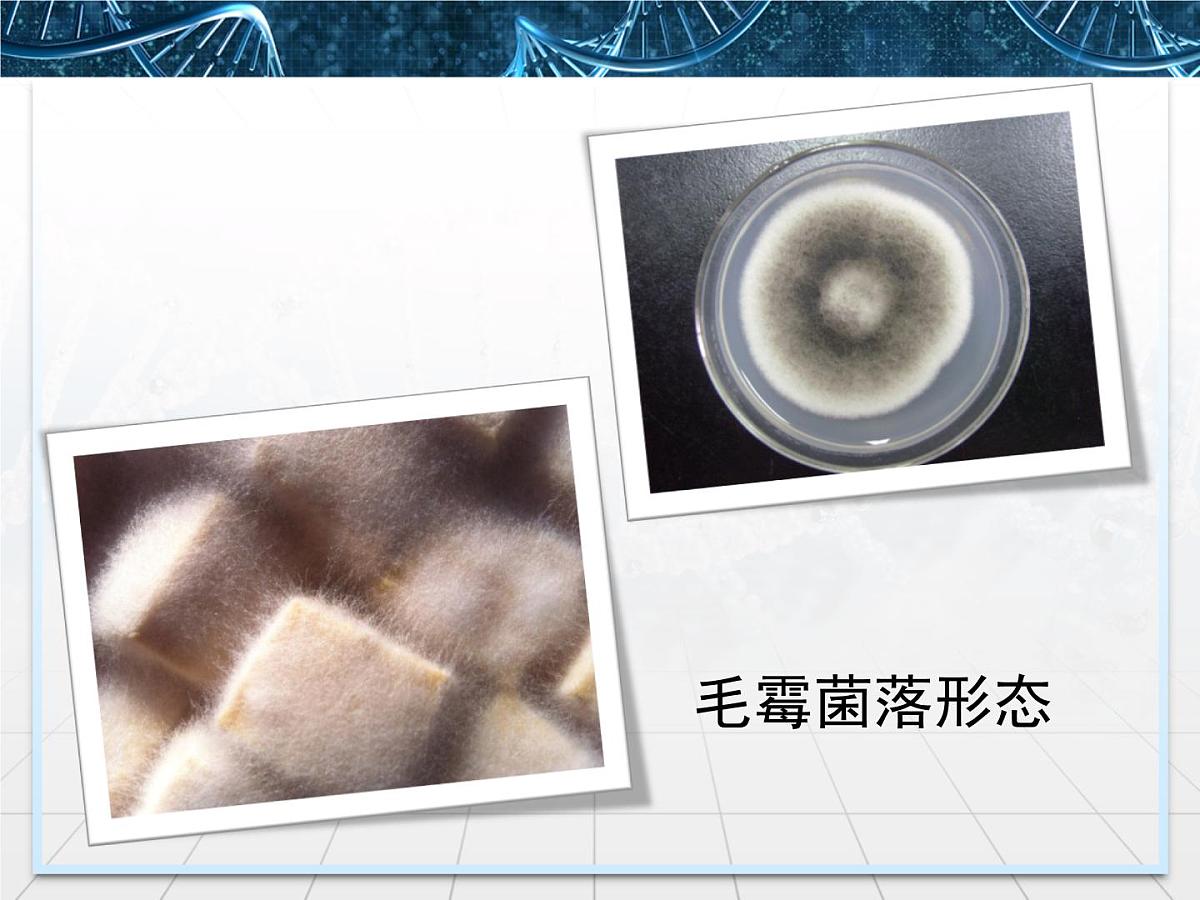
人教版 (新课标)高中生物选修1 1-2《腐乳的制作》课件第8页

高中人教版 (新课标)腐乳的制作备课课件ppt
展开
这是一份高中人教版 (新课标)腐乳的制作备课课件ppt,共27页。PPT课件主要包含了基础知识,实验过程,关于毛霉,孢子生殖,异养需氧型,毛霉菌落形态,二腐乳制作的原理,思考题,1前期发酵,2后期发酵等内容,欢迎下载使用。
为何臭豆腐“闻着臭,吃着香”呢?
原来是豆腐在发酵时,毛霉菌种在较高温度的作用下使豆腐中的蛋白质分解成含硫氨基酸,进而分解成少量的硫化氢气体,硫化氢有刺激性的臭味,因而叫臭豆腐。由于臭豆腐中含有大量的氨基酸,而氨基酸有鲜美的味道,所以臭豆腐的“臭”并不影响它的“香”,吃起来也就回味无穷了。
1.通过阅读教材,结合教师讲解,能够说明腐乳制作过程的科学原理,设计并完成腐乳的制作。2.通过观看腐乳的制作视频,结合实验操作,能够分析出影响腐乳品质的条件,并能认识统发酵技术的应用。
(一)参与腐乳制作的微生物
分类:代谢类型:生殖(主要方式):分布:
丝状真菌(具发达的白色菌丝)
常见于土壤、水果、蔬菜、谷物上
1.腐乳酿造的微生物种类十分复杂,起主要作用的是毛霉。2.豆腐坯用食盐腌制,使渗透盐分析出水分,给腐乳以必要的咸味,食盐又能防止毛霉继续生长和污染的杂菌繁殖。此外还具有浸提毛霉菌丝上的蛋白酶的作用。
我们平常吃的豆腐,哪种适合用来做腐乳?为什么呢?
答:含水量为70%左右的豆腐适于作腐乳。用含水量过高的豆腐制腐乳,不易成形。
2.吃腐乳时,你会发现腐乳外部有一层致密的“皮”。这层“皮”是怎样形成的呢?它对人体有害吗?它的作用是什么?
答:“皮”是前期发酵时在豆腐表面上生长的菌丝(匍匐菌丝),它能形成腐乳的“体”,使腐乳成形。“皮”对人体无害。
增加风味和口感控制毛霉的生长
毛霉的生长:将豆腐块平放在笼屉内,将笼屉中的温度控制在15℃~18℃,并保持一定湿度。约48h后,毛霉开始生长,3d之后菌丝生长旺盛,5d后豆腐块表面布满菌丝。
①加盐腌制:将长满毛霉的豆腐块分层整齐地摆放在瓶中,同时逐层加盐,随着层数的加高而增加盐量,接近瓶口表面的盐要铺厚一些。加盐腌制的时间约为8d左右。
②配制卤汤:配料与贮藏是腐乳后熟的关键。配料前先把腌坯取出,搓开,再计数装入干燥的瓶内,并根据不同品种给予不同配料。
③密封腌制:封瓶时,最好将瓶口通过酒精灯的火焰,防止瓶口被污染。腐乳的后期发酵,即后熟期主要是在贮藏期间进行。由于豆腐坯上生长的微生物与所加入的配料中的微生物,在贮藏期间引起复杂的生物化学作用,从而促使豆腐乳的成熟。
腐乳贮藏到一定时间,当感官鉴定舌觉细腻而柔糯后,即得已成熟的成品,但各种品种还须各具特色。
例如:小红方,具有红腐乳特有的香气,表面有鲜艳的红色,断面淡黄色,味咸而鲜,质柔糯。
1.豆腐块上生长的毛霉来源?
(1)可以析出豆腐中的水分,使豆腐变硬 (2)抑制微生物的生长,避免豆腐块腐败变质。
A.是否完成腐乳的制作
能够合理的选择实验材料与用具;
前期发酵后豆腐的表面长有菌丝;后期发酵制作基本没有杂菌的污染。
成功的腐乳应具有以下特点:
色泽基本一致、味道鲜美、咸淡适口、无异味、块形整齐、厚薄均匀、质地细腻、无杂质。
C.能否总结不同条件对腐乳风味和质量的影响
从盐、酒的用量、发酵的温度、发酵时间的长短、以及香辛料等因素中的某一因素说明其对腐乳风味或质量的影响。
1.现代科学研究表明,多种微生物参与了腐乳的发酵,其中起主要作用的是( ) A.青霉 B.曲霉 C.毛霉 D.根霉
解析:酿制腐乳现在大多已应用纯菌种接种于豆腐坯上,由于在敞开的自然条件下培养,外界的微生物难免侵入,加上配料中也带有微生物,所以腐乳酿造微生物种类十分复杂。包括四大霉菌、酵母菌、各种细菌,但毛霉占主要地位。答案:C
2.毛霉的代谢类型( )A.自养需氧 B.异养需氧 C.异养厌氧 D.异养兼性厌氧
解析:毛霉代谢过程中需从外界摄取营养物质,维持自己的生活,主要进行有氧呼吸,亦可进行无氧呼吸。答案:D
3.豆腐坯用食盐腌制,其作用是( )①渗透盐分,析出水分②给腐乳以必要的咸味③防止毛霉继续生长和污染的杂菌繁殖④浸提毛霉菌丝上的蛋白酶A.①②③ B.②③④ C.①③④ D.①②③④
相关课件 更多
- 1.电子资料成功下载后不支持退换,如发现资料有内容错误问题请联系客服,如若属实,我们会补偿您的损失
- 2.压缩包下载后请先用软件解压,再使用对应软件打开;软件版本较低时请及时更新
- 3.资料下载成功后可在60天以内免费重复下载
 免费领取教师福利
免费领取教师福利


.png)




